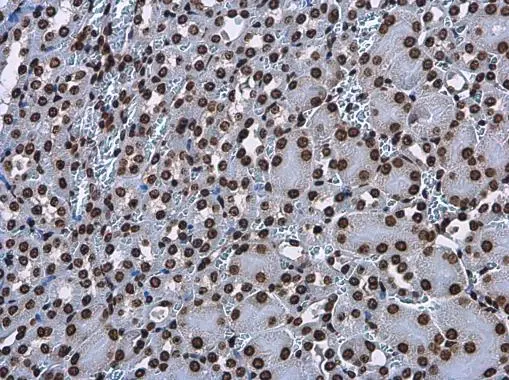
Histone H3.3B antibody detects Histone H3.3B protein at nucleus in mouse kidney by immunohistochemical analysis. Sample: Paraffin-embedded mouse kidney. Histone H3.3B antibody (GTX115549) diluted at 1:500.
Antigen Retrieval: Citrate buffer, pH 6.0, 15 min Histone H3.3B antibody detects Histone H3.3B protein at nucleus in mouse kidney by immunohistochemical analysis. Sample: Paraffin-embedded mouse kidney. Histone H3.3B antibody (GTX115549) diluted at 1:500.
Antigen Retrieval: Citrate buffer, pH 6.0, 15 min

Histone H3.3B antibody detects Histone H3.3B protein at nucleus in rat brain by immunohistochemical analysis. Sample: Paraffin-embedded rat brain. Histone H3.3B antibody (GTX115549) diluted at 1:500.
Antigen Retrieval: Citrate buffer, pH 6.0, 15 min
Histone H3.3B antibody
GTX115549
ApplicationsImmunoFluorescence, Western Blot, ImmunoCytoChemistry, ImmunoHistoChemistry, ImmunoHistoChemistry Paraffin
Product group Antibodies
ReactivityHuman, Mouse, Rat
TargetH3-3A
Overview
- SupplierGeneTex
- Product NameHistone H3.3B antibody
- Delivery Days Customer9
- Application Supplier NoteWB: 1:500-1:20000. ICC/IF: 1:100-1:1000. IHC-P: 1:100-1:1000. *Optimal dilutions/concentrations should be determined by the researcher.Not tested in other applications.
- ApplicationsImmunoFluorescence, Western Blot, ImmunoCytoChemistry, ImmunoHistoChemistry, ImmunoHistoChemistry Paraffin
- CertificationResearch Use Only
- ClonalityPolyclonal
- Concentration0.16 mg/ml
- ConjugateUnconjugated
- Gene ID3020
- Target nameH3-3A
- Target descriptionH3.3 histone A
- Target synonymsBRYLIB1, H3.3A, H3F3, H3F3A, histone H3.3, H3 histone family member 3A, H3 histone, family 3A
- HostRabbit
- IsotypeIgG
- Protein IDP84243
- Protein NameHistone H3.3
- Scientific DescriptionHistones are basic nuclear proteins that are responsible for the nucleosome structure of the chromosomal fiber in eukaryotes. Two molecules of each of the four core histones (H2A, H2B, H3, and H4) form an octamer, around which approximately 146 bp of DNA is wrapped in repeating units, called nucleosomes. The linker histone, H1, interacts with linker DNA between nucleosomes and functions in the compaction of chromatin into higher order structures. This gene contains introns and its mRNA is polyadenylated, unlike most histone genes. The protein encoded by this gene is a replication-independent histone that is a member of the histone H3 family. Pseudogenes of this gene have been identified on the X chromosome, and on chromosomes 5, 13 and 17. [provided by RefSeq, Oct 2015]
- ReactivityHuman, Mouse, Rat
- Storage Instruction-20°C or -80°C,2°C to 8°C
- UNSPSC12352203
References
- Hsu CL, Yin CF, Chang YW, et al. LncRNA SNHG1 regulates neuroblastoma cell fate via interactions with HDAC1/2. Cell Death Dis. 2022,13(9):809. doi: 10.1038/s41419-022-05256-zRead this paper
- Lee LC, Su MT, Huang HY, et al. Association of CaMK2A and MeCP2 signaling pathways with cognitive ability in adolescents. Mol Brain. 2021,14(1):152. doi: 10.1186/s13041-021-00858-8Read this paper
- Lee LC, Su MT, Cho YC, et al. Multiple epigenetic biomarkers for evaluation of students' academic performance. Genes Brain Behav. 2019,18(5):e12559. doi: 10.1111/gbb.12559Read this paper
- Maity J, Das B, Bohr VA, et al. Acidic domain of WRNp is critical for autophagy and up-regulates age associated proteins. DNA Repair (Amst). 2018,68:1-11. doi: 10.1016/j.dnarep.2018.05.003Read this paper
- Schroeder M, Jakovcevski M, Polacheck T, et al. Placental miR-340 mediates vulnerability to activity based anorexia in mice. Nat Commun. 2018,9(1):1596. doi: 10.1038/s41467-018-03836-2Read this paper
- Lee LC, Chen CM, Wang PR, et al. Role of high mobility group box 1 (HMGB1) in SCA17 pathogenesis. PLoS One. 2014,9(12):e115809. doi: 10.1371/journal.pone.0115809Read this paper
- Chang KH, Chen WL, Lee LC, et al. Aqueous Extract of Paeonia lactiflora and Paeoniflorin as Aggregation Reducers Targeting Chaperones in Cell Models of Spinocerebellar Ataxia 3. Evid Based Complement Alternat Med. 2013,2013:471659. doi: 10.1155/2013/471659Read this paper